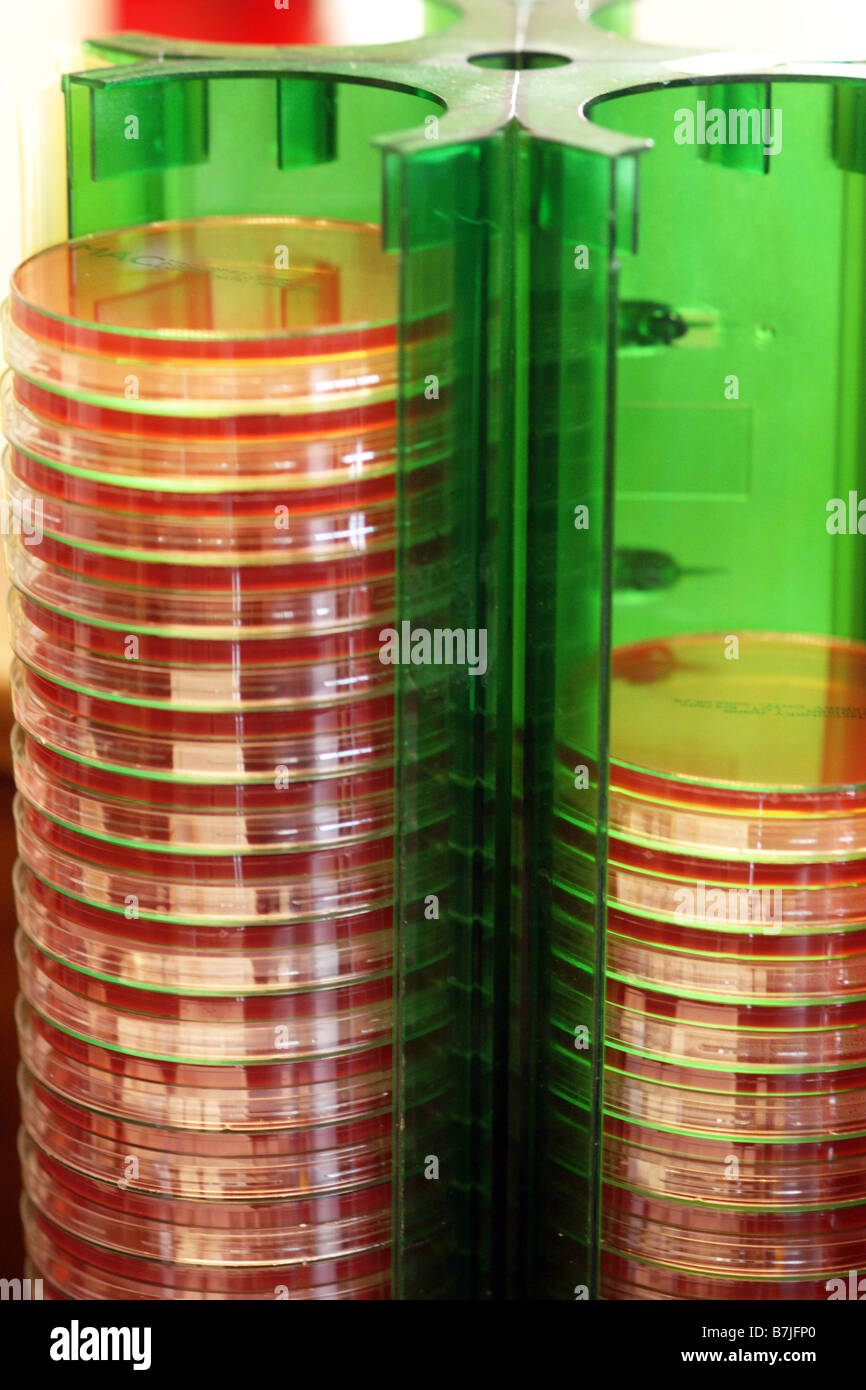
Petrischalen in ein Krankenhaus labatory Stockfoto

Schnellfilter:
Den abwasch machen Stockfotos & Bilder
 Teller und Schüsseln Stockfotohttps://www.alamy.de/image-license-details/?v=1https://www.alamy.de/stockfoto-teller-und-schusseln-54228813.html
Teller und Schüsseln Stockfotohttps://www.alamy.de/image-license-details/?v=1https://www.alamy.de/stockfoto-teller-und-schusseln-54228813.htmlRFD469B9–Teller und Schüsseln
 Studioaufnahme von schmutzigen, weißen Geschirr gestapelt Stockfotohttps://www.alamy.de/image-license-details/?v=1https://www.alamy.de/stockfoto-studioaufnahme-von-schmutzigen-weissen-geschirr-gestapelt-41838493.html
Studioaufnahme von schmutzigen, weißen Geschirr gestapelt Stockfotohttps://www.alamy.de/image-license-details/?v=1https://www.alamy.de/stockfoto-studioaufnahme-von-schmutzigen-weissen-geschirr-gestapelt-41838493.htmlRFCC1WBW–Studioaufnahme von schmutzigen, weißen Geschirr gestapelt
 Hispanic Frau weglegen Geschirr in Spülmaschine Stockfotohttps://www.alamy.de/image-license-details/?v=1https://www.alamy.de/stockfoto-hispanic-frau-weglegen-geschirr-in-spulmaschine-30134209.html
Hispanic Frau weglegen Geschirr in Spülmaschine Stockfotohttps://www.alamy.de/image-license-details/?v=1https://www.alamy.de/stockfoto-hispanic-frau-weglegen-geschirr-in-spulmaschine-30134209.htmlRFBN0MDN–Hispanic Frau weglegen Geschirr in Spülmaschine
 Mann mit Bart und Plaid Shirt Abwasch zu Hause. Stockfotohttps://www.alamy.de/image-license-details/?v=1https://www.alamy.de/mann-mit-bart-und-plaid-shirt-abwasch-zu-hause-image256227965.html
Mann mit Bart und Plaid Shirt Abwasch zu Hause. Stockfotohttps://www.alamy.de/image-license-details/?v=1https://www.alamy.de/mann-mit-bart-und-plaid-shirt-abwasch-zu-hause-image256227965.htmlRFTTT5AN–Mann mit Bart und Plaid Shirt Abwasch zu Hause.
 AUSWAHL AN INDISCHEN CURRY-GERICHTE Stockfotohttps://www.alamy.de/image-license-details/?v=1https://www.alamy.de/stockfoto-auswahl-an-indischen-curry-gerichte-85762739.html
AUSWAHL AN INDISCHEN CURRY-GERICHTE Stockfotohttps://www.alamy.de/image-license-details/?v=1https://www.alamy.de/stockfoto-auswahl-an-indischen-curry-gerichte-85762739.htmlRFEYER6Y–AUSWAHL AN INDISCHEN CURRY-GERICHTE
 Gerichte der lokalen Meeresfrüchte in einem Restaurant in Zhangzhou, Fujian, China. Stockfotohttps://www.alamy.de/image-license-details/?v=1https://www.alamy.de/stockfoto-gerichte-der-lokalen-meeresfruchte-in-einem-restaurant-in-zhangzhou-fujian-china-24145000.html
Gerichte der lokalen Meeresfrüchte in einem Restaurant in Zhangzhou, Fujian, China. Stockfotohttps://www.alamy.de/image-license-details/?v=1https://www.alamy.de/stockfoto-gerichte-der-lokalen-meeresfruchte-in-einem-restaurant-in-zhangzhou-fujian-china-24145000.htmlRMBB7W5C–Gerichte der lokalen Meeresfrüchte in einem Restaurant in Zhangzhou, Fujian, China.
 Gastronomie, Gerichte, Speisen, Kanton Graubünden, Graubünden, GR, Oberengadin, Essen, Essen, Gastronomie, Restaurant, Hotel, Schweiz Stockfotohttps://www.alamy.de/image-license-details/?v=1https://www.alamy.de/stockfoto-gastronomie-gerichte-speisen-kanton-graubunden-graubunden-gr-oberengadin-essen-essen-gastronomie-restaurant-hotel-schweiz-73626397.html
Gastronomie, Gerichte, Speisen, Kanton Graubünden, Graubünden, GR, Oberengadin, Essen, Essen, Gastronomie, Restaurant, Hotel, Schweiz Stockfotohttps://www.alamy.de/image-license-details/?v=1https://www.alamy.de/stockfoto-gastronomie-gerichte-speisen-kanton-graubunden-graubunden-gr-oberengadin-essen-essen-gastronomie-restaurant-hotel-schweiz-73626397.htmlRME7NY65–Gastronomie, Gerichte, Speisen, Kanton Graubünden, Graubünden, GR, Oberengadin, Essen, Essen, Gastronomie, Restaurant, Hotel, Schweiz
 Gerichte mit verschiedenen Farben der Böden Stockfotohttps://www.alamy.de/image-license-details/?v=1https://www.alamy.de/stockfoto-gerichte-mit-verschiedenen-farben-der-boden-76129294.html
Gerichte mit verschiedenen Farben der Böden Stockfotohttps://www.alamy.de/image-license-details/?v=1https://www.alamy.de/stockfoto-gerichte-mit-verschiedenen-farben-der-boden-76129294.htmlRMEBRYKA–Gerichte mit verschiedenen Farben der Böden
 Traditionelle Gerichte mit marokkanischen Salaten Stockfotohttps://www.alamy.de/image-license-details/?v=1https://www.alamy.de/stockfoto-traditionelle-gerichte-mit-marokkanischen-salaten-94169326.html
Traditionelle Gerichte mit marokkanischen Salaten Stockfotohttps://www.alamy.de/image-license-details/?v=1https://www.alamy.de/stockfoto-traditionelle-gerichte-mit-marokkanischen-salaten-94169326.htmlRFFD5NX6–Traditionelle Gerichte mit marokkanischen Salaten
 Auswahl an warmen Fleischgerichten und Erdbeer-Wüste Stockfotohttps://www.alamy.de/image-license-details/?v=1https://www.alamy.de/stockfoto-auswahl-an-warmen-fleischgerichten-und-erdbeer-wuste-13896361.html
Auswahl an warmen Fleischgerichten und Erdbeer-Wüste Stockfotohttps://www.alamy.de/image-license-details/?v=1https://www.alamy.de/stockfoto-auswahl-an-warmen-fleischgerichten-und-erdbeer-wuste-13896361.htmlRMAFBMTX–Auswahl an warmen Fleischgerichten und Erdbeer-Wüste
 Balaleet, Harees und Margoog traditionellen persischen Golf Arabisch Küche Gerichte im Café im Souk von Manama, Bahrain Stockfotohttps://www.alamy.de/image-license-details/?v=1https://www.alamy.de/stockfoto-balaleet-harees-und-margoog-traditionellen-persischen-golf-arabisch-kuche-gerichte-im-caf-im-souk-von-manama-bahrain-109160180.html
Balaleet, Harees und Margoog traditionellen persischen Golf Arabisch Küche Gerichte im Café im Souk von Manama, Bahrain Stockfotohttps://www.alamy.de/image-license-details/?v=1https://www.alamy.de/stockfoto-balaleet-harees-und-margoog-traditionellen-persischen-golf-arabisch-kuche-gerichte-im-caf-im-souk-von-manama-bahrain-109160180.htmlRMG9GJWT–Balaleet, Harees und Margoog traditionellen persischen Golf Arabisch Küche Gerichte im Café im Souk von Manama, Bahrain
 Fleischgerichte im Restaurant Laguna Grande, Nationalpark Garajonay, La Gomera, Kanarische Inseln, Spanien, Europa Stockfotohttps://www.alamy.de/image-license-details/?v=1https://www.alamy.de/stockfoto-fleischgerichte-im-restaurant-laguna-grande-nationalpark-garajonay-la-gomera-kanarische-inseln-spanien-europa-21699662.html
Fleischgerichte im Restaurant Laguna Grande, Nationalpark Garajonay, La Gomera, Kanarische Inseln, Spanien, Europa Stockfotohttps://www.alamy.de/image-license-details/?v=1https://www.alamy.de/stockfoto-fleischgerichte-im-restaurant-laguna-grande-nationalpark-garajonay-la-gomera-kanarische-inseln-spanien-europa-21699662.htmlRMB78E3X–Fleischgerichte im Restaurant Laguna Grande, Nationalpark Garajonay, La Gomera, Kanarische Inseln, Spanien, Europa
 Osias Beert, Gerichte mit Austern, Obst und Wein 1620-1625 Öl auf Holz. National Gallery of Art, Washington, D.C. Stockfotohttps://www.alamy.de/image-license-details/?v=1https://www.alamy.de/osias-beert-gerichte-mit-austern-obst-und-wein-1620-1625-ol-auf-holz-national-gallery-of-art-washington-dc-image62059574.html
Osias Beert, Gerichte mit Austern, Obst und Wein 1620-1625 Öl auf Holz. National Gallery of Art, Washington, D.C. Stockfotohttps://www.alamy.de/image-license-details/?v=1https://www.alamy.de/osias-beert-gerichte-mit-austern-obst-und-wein-1620-1625-ol-auf-holz-national-gallery-of-art-washington-dc-image62059574.htmlRMDGY1HA–Osias Beert, Gerichte mit Austern, Obst und Wein 1620-1625 Öl auf Holz. National Gallery of Art, Washington, D.C.
 Petrischalen und anderen Biiological Proben im Kühlschrank von einem Biotechnologie-Labor Stockfotohttps://www.alamy.de/image-license-details/?v=1https://www.alamy.de/stockfoto-petrischalen-und-anderen-biiological-proben-im-kuhlschrank-von-einem-biotechnologie-labor-89580617.html
Petrischalen und anderen Biiological Proben im Kühlschrank von einem Biotechnologie-Labor Stockfotohttps://www.alamy.de/image-license-details/?v=1https://www.alamy.de/stockfoto-petrischalen-und-anderen-biiological-proben-im-kuhlschrank-von-einem-biotechnologie-labor-89580617.htmlRMF5MMYN–Petrischalen und anderen Biiological Proben im Kühlschrank von einem Biotechnologie-Labor
 Spüle voller schmutziges Geschirr Stockfotohttps://www.alamy.de/image-license-details/?v=1https://www.alamy.de/stockfoto-spule-voller-schmutziges-geschirr-20857662.html
Spüle voller schmutziges Geschirr Stockfotohttps://www.alamy.de/image-license-details/?v=1https://www.alamy.de/stockfoto-spule-voller-schmutziges-geschirr-20857662.htmlRFB5X44E–Spüle voller schmutziges Geschirr
 Gerichte von Konnyaku Stockfotohttps://www.alamy.de/image-license-details/?v=1https://www.alamy.de/stockfoto-gerichte-von-konnyaku-37140819.html
Gerichte von Konnyaku Stockfotohttps://www.alamy.de/image-license-details/?v=1https://www.alamy.de/stockfoto-gerichte-von-konnyaku-37140819.htmlRFC4BWDR–Gerichte von Konnyaku
 Bosnische Gerichte auf den Tisch Stockfotohttps://www.alamy.de/image-license-details/?v=1https://www.alamy.de/stockfoto-bosnische-gerichte-auf-den-tisch-79323720.html
Bosnische Gerichte auf den Tisch Stockfotohttps://www.alamy.de/image-license-details/?v=1https://www.alamy.de/stockfoto-bosnische-gerichte-auf-den-tisch-79323720.htmlRMEH1E60–Bosnische Gerichte auf den Tisch
 Brötchen und Brot in Scheiben geschnitten Gerichte mit Chutney gelegt auf einem Tisch Pune Maharashtra Indien Asien Stockfotohttps://www.alamy.de/image-license-details/?v=1https://www.alamy.de/stockfoto-brotchen-und-brot-in-scheiben-geschnitten-gerichte-mit-chutney-gelegt-auf-einem-tisch-pune-maharashtra-indien-asien-83631055.html
Brötchen und Brot in Scheiben geschnitten Gerichte mit Chutney gelegt auf einem Tisch Pune Maharashtra Indien Asien Stockfotohttps://www.alamy.de/image-license-details/?v=1https://www.alamy.de/stockfoto-brotchen-und-brot-in-scheiben-geschnitten-gerichte-mit-chutney-gelegt-auf-einem-tisch-pune-maharashtra-indien-asien-83631055.htmlRMET1M7B–Brötchen und Brot in Scheiben geschnitten Gerichte mit Chutney gelegt auf einem Tisch Pune Maharashtra Indien Asien
 Familie macht Geschirr in der Küche Waschbecken Stockfotohttps://www.alamy.de/image-license-details/?v=1https://www.alamy.de/familie-macht-geschirr-in-der-kuche-waschbecken-image360957498.html
Familie macht Geschirr in der Küche Waschbecken Stockfotohttps://www.alamy.de/image-license-details/?v=1https://www.alamy.de/familie-macht-geschirr-in-der-kuche-waschbecken-image360957498.htmlRF2BY70Y6–Familie macht Geschirr in der Küche Waschbecken
 Speisen zubereitet von einem Koch Restaurant Zubereitung Speisen Industrie Stockfotohttps://www.alamy.de/image-license-details/?v=1https://www.alamy.de/stockfoto-speisen-zubereitet-von-einem-koch-restaurant-zubereitung-speisen-industrie-140085717.html
Speisen zubereitet von einem Koch Restaurant Zubereitung Speisen Industrie Stockfotohttps://www.alamy.de/image-license-details/?v=1https://www.alamy.de/stockfoto-speisen-zubereitet-von-einem-koch-restaurant-zubereitung-speisen-industrie-140085717.htmlRMJ3WCN9–Speisen zubereitet von einem Koch Restaurant Zubereitung Speisen Industrie
 Stapel von Gerichten Stockfotohttps://www.alamy.de/image-license-details/?v=1https://www.alamy.de/stockfoto-stapel-von-gerichten-44011421.html
Stapel von Gerichten Stockfotohttps://www.alamy.de/image-license-details/?v=1https://www.alamy.de/stockfoto-stapel-von-gerichten-44011421.htmlRMCFGW0D–Stapel von Gerichten
 Alten nepalesischen Frau wäscht Geschirr mit Wasser aus einem Brunnen außerhalb Stockfotohttps://www.alamy.de/image-license-details/?v=1https://www.alamy.de/stockfoto-alten-nepalesischen-frau-wascht-geschirr-mit-wasser-aus-einem-brunnen-ausserhalb-92362479.html
Alten nepalesischen Frau wäscht Geschirr mit Wasser aus einem Brunnen außerhalb Stockfotohttps://www.alamy.de/image-license-details/?v=1https://www.alamy.de/stockfoto-alten-nepalesischen-frau-wascht-geschirr-mit-wasser-aus-einem-brunnen-ausserhalb-92362479.htmlRFFA7D7Y–Alten nepalesischen Frau wäscht Geschirr mit Wasser aus einem Brunnen außerhalb
 Viele Satellitenschüsseln fest mit Balkon des Wohnhauses gebaut als Sozialwohnungen am Pallasstraße in Schöneberg Berlin Stockfotohttps://www.alamy.de/image-license-details/?v=1https://www.alamy.de/stockfoto-viele-satellitenschusseln-fest-mit-balkon-des-wohnhauses-gebaut-als-sozialwohnungen-am-pallasstrasse-in-schoneberg-berlin-20271636.html
Viele Satellitenschüsseln fest mit Balkon des Wohnhauses gebaut als Sozialwohnungen am Pallasstraße in Schöneberg Berlin Stockfotohttps://www.alamy.de/image-license-details/?v=1https://www.alamy.de/stockfoto-viele-satellitenschusseln-fest-mit-balkon-des-wohnhauses-gebaut-als-sozialwohnungen-am-pallasstrasse-in-schoneberg-berlin-20271636.htmlRMB4YCK0–Viele Satellitenschüsseln fest mit Balkon des Wohnhauses gebaut als Sozialwohnungen am Pallasstraße in Schöneberg Berlin
 AUSWAHL AN INDISCHEN CURRY-GERICHTE Stockfotohttps://www.alamy.de/image-license-details/?v=1https://www.alamy.de/stockfoto-auswahl-an-indischen-curry-gerichte-85762742.html
AUSWAHL AN INDISCHEN CURRY-GERICHTE Stockfotohttps://www.alamy.de/image-license-details/?v=1https://www.alamy.de/stockfoto-auswahl-an-indischen-curry-gerichte-85762742.htmlRFEYER72–AUSWAHL AN INDISCHEN CURRY-GERICHTE
 Gerichte in einem Restaurant in Quanzhou, Fujian, China. Stockfotohttps://www.alamy.de/image-license-details/?v=1https://www.alamy.de/stockfoto-gerichte-in-einem-restaurant-in-quanzhou-fujian-china-24145573.html
Gerichte in einem Restaurant in Quanzhou, Fujian, China. Stockfotohttps://www.alamy.de/image-license-details/?v=1https://www.alamy.de/stockfoto-gerichte-in-einem-restaurant-in-quanzhou-fujian-china-24145573.htmlRMBB7WWW–Gerichte in einem Restaurant in Quanzhou, Fujian, China.
 Gastronomie, Gerichte, Speisen, Kanton Graubünden, Graubünden, GR, Oberengadin, Essen, Essen, Gastronomie, Restaurant, Hotel, Schweiz Stockfotohttps://www.alamy.de/image-license-details/?v=1https://www.alamy.de/stockfoto-gastronomie-gerichte-speisen-kanton-graubunden-graubunden-gr-oberengadin-essen-essen-gastronomie-restaurant-hotel-schweiz-73626398.html
Gastronomie, Gerichte, Speisen, Kanton Graubünden, Graubünden, GR, Oberengadin, Essen, Essen, Gastronomie, Restaurant, Hotel, Schweiz Stockfotohttps://www.alamy.de/image-license-details/?v=1https://www.alamy.de/stockfoto-gastronomie-gerichte-speisen-kanton-graubunden-graubunden-gr-oberengadin-essen-essen-gastronomie-restaurant-hotel-schweiz-73626398.htmlRME7NY66–Gastronomie, Gerichte, Speisen, Kanton Graubünden, Graubünden, GR, Oberengadin, Essen, Essen, Gastronomie, Restaurant, Hotel, Schweiz
 Radioteleskop Satellitenschüssel Gerichte der Sternwarte Very Large Array VLA in der Nähe von Socorro New Mexico uns USA Amerika Stockfotohttps://www.alamy.de/image-license-details/?v=1https://www.alamy.de/stockfoto-radioteleskop-satellitenschussel-gerichte-der-sternwarte-very-large-array-vla-in-der-nahe-von-socorro-new-mexico-uns-usa-amerika-13125600.html
Radioteleskop Satellitenschüssel Gerichte der Sternwarte Very Large Array VLA in der Nähe von Socorro New Mexico uns USA Amerika Stockfotohttps://www.alamy.de/image-license-details/?v=1https://www.alamy.de/stockfoto-radioteleskop-satellitenschussel-gerichte-der-sternwarte-very-large-array-vla-in-der-nahe-von-socorro-new-mexico-uns-usa-amerika-13125600.htmlRMACDPXW–Radioteleskop Satellitenschüssel Gerichte der Sternwarte Very Large Array VLA in der Nähe von Socorro New Mexico uns USA Amerika
 Gerichte mit marokkanischen festliche hausgemachte Kekse und Tee Stockfotohttps://www.alamy.de/image-license-details/?v=1https://www.alamy.de/stockfoto-gerichte-mit-marokkanischen-festliche-hausgemachte-kekse-und-tee-101931633.html
Gerichte mit marokkanischen festliche hausgemachte Kekse und Tee Stockfotohttps://www.alamy.de/image-license-details/?v=1https://www.alamy.de/stockfoto-gerichte-mit-marokkanischen-festliche-hausgemachte-kekse-und-tee-101931633.htmlRFFWRARD–Gerichte mit marokkanischen festliche hausgemachte Kekse und Tee
 Rustikale Gerichte von einem Mittagsbuffet im mittelalterlichen Restaurant Stockfotohttps://www.alamy.de/image-license-details/?v=1https://www.alamy.de/stockfoto-rustikale-gerichte-von-einem-mittagsbuffet-im-mittelalterlichen-restaurant-175291723.html
Rustikale Gerichte von einem Mittagsbuffet im mittelalterlichen Restaurant Stockfotohttps://www.alamy.de/image-license-details/?v=1https://www.alamy.de/stockfoto-rustikale-gerichte-von-einem-mittagsbuffet-im-mittelalterlichen-restaurant-175291723.htmlRMM556AK–Rustikale Gerichte von einem Mittagsbuffet im mittelalterlichen Restaurant
 Geschirr abwaschen Stockfotohttps://www.alamy.de/image-license-details/?v=1https://www.alamy.de/geschirr-abwaschen-image372500413.html
Geschirr abwaschen Stockfotohttps://www.alamy.de/image-license-details/?v=1https://www.alamy.de/geschirr-abwaschen-image372500413.htmlRM2CJ0T25–Geschirr abwaschen
 Chinesische Künstler jonglieren Gerichte Stockfotohttps://www.alamy.de/image-license-details/?v=1https://www.alamy.de/stockfoto-chinesische-kunstler-jonglieren-gerichte-16638194.html
Chinesische Künstler jonglieren Gerichte Stockfotohttps://www.alamy.de/image-license-details/?v=1https://www.alamy.de/stockfoto-chinesische-kunstler-jonglieren-gerichte-16638194.htmlRMAWR52Y–Chinesische Künstler jonglieren Gerichte
 Eine Reihe von entree Gerichte mit der preußischen Wappen, von einem Service Made in China für Friedrich, 1750 Stockfotohttps://www.alamy.de/image-license-details/?v=1https://www.alamy.de/eine-reihe-von-entree-gerichte-mit-der-preussischen-wappen-von-einem-service-made-in-china-fur-friedrich-1750-image268797360.html
Eine Reihe von entree Gerichte mit der preußischen Wappen, von einem Service Made in China für Friedrich, 1750 Stockfotohttps://www.alamy.de/image-license-details/?v=1https://www.alamy.de/eine-reihe-von-entree-gerichte-mit-der-preussischen-wappen-von-einem-service-made-in-china-fur-friedrich-1750-image268797360.htmlRMWH8NNM–Eine Reihe von entree Gerichte mit der preußischen Wappen, von einem Service Made in China für Friedrich, 1750
 Eine Frau legt Schalen, Töpfe und Geschirr auf einem erhöhten Geschirrablage verwendet, um Speisen sie stattdessen direkt auf dem Boden liegend trocknen Stockfotohttps://www.alamy.de/image-license-details/?v=1https://www.alamy.de/stockfoto-eine-frau-legt-schalen-topfe-und-geschirr-auf-einem-erhohten-geschirrablage-verwendet-um-speisen-sie-stattdessen-direkt-auf-dem-boden-liegend-trocknen-48871619.html
Eine Frau legt Schalen, Töpfe und Geschirr auf einem erhöhten Geschirrablage verwendet, um Speisen sie stattdessen direkt auf dem Boden liegend trocknen Stockfotohttps://www.alamy.de/image-license-details/?v=1https://www.alamy.de/stockfoto-eine-frau-legt-schalen-topfe-und-geschirr-auf-einem-erhohten-geschirrablage-verwendet-um-speisen-sie-stattdessen-direkt-auf-dem-boden-liegend-trocknen-48871619.htmlRMCRE86Y–Eine Frau legt Schalen, Töpfe und Geschirr auf einem erhöhten Geschirrablage verwendet, um Speisen sie stattdessen direkt auf dem Boden liegend trocknen
 Frau Reinigung Geschirr Stockfotohttps://www.alamy.de/image-license-details/?v=1https://www.alamy.de/stockfoto-frau-reinigung-geschirr-20280818.html
Frau Reinigung Geschirr Stockfotohttps://www.alamy.de/image-license-details/?v=1https://www.alamy.de/stockfoto-frau-reinigung-geschirr-20280818.htmlRFB4YTAX–Frau Reinigung Geschirr
 Gerichte von Konnyaku Stockfotohttps://www.alamy.de/image-license-details/?v=1https://www.alamy.de/stockfoto-gerichte-von-konnyaku-37140822.html
Gerichte von Konnyaku Stockfotohttps://www.alamy.de/image-license-details/?v=1https://www.alamy.de/stockfoto-gerichte-von-konnyaku-37140822.htmlRFC4BWDX–Gerichte von Konnyaku
 Frau wischte sich die Gerichte. Stockfotohttps://www.alamy.de/image-license-details/?v=1https://www.alamy.de/stockfoto-frau-wischte-sich-die-gerichte-91225483.html
Frau wischte sich die Gerichte. Stockfotohttps://www.alamy.de/image-license-details/?v=1https://www.alamy.de/stockfoto-frau-wischte-sich-die-gerichte-91225483.htmlRMF8BK0Y–Frau wischte sich die Gerichte.
 Zwei alte Parabolantennen an der Wand einer inländischen Eigenschaft in Irland. Stockfotohttps://www.alamy.de/image-license-details/?v=1https://www.alamy.de/stockfoto-zwei-alte-parabolantennen-an-der-wand-einer-inlandischen-eigenschaft-in-irland-133042302.html
Zwei alte Parabolantennen an der Wand einer inländischen Eigenschaft in Irland. Stockfotohttps://www.alamy.de/image-license-details/?v=1https://www.alamy.de/stockfoto-zwei-alte-parabolantennen-an-der-wand-einer-inlandischen-eigenschaft-in-irland-133042302.htmlRMHMCGPP–Zwei alte Parabolantennen an der Wand einer inländischen Eigenschaft in Irland.
 Familie macht Geschirr in der Küche Stockfotohttps://www.alamy.de/image-license-details/?v=1https://www.alamy.de/familie-macht-geschirr-in-der-kuche-image360957629.html
Familie macht Geschirr in der Küche Stockfotohttps://www.alamy.de/image-license-details/?v=1https://www.alamy.de/familie-macht-geschirr-in-der-kuche-image360957629.htmlRF2BY713W–Familie macht Geschirr in der Küche
 Ein Tisch in einem Restaurant mit dreckigem Geschirr nach dem Essen. Stockfotohttps://www.alamy.de/image-license-details/?v=1https://www.alamy.de/ein-tisch-in-einem-restaurant-mit-dreckigem-geschirr-nach-dem-essen-image552161781.html
Ein Tisch in einem Restaurant mit dreckigem Geschirr nach dem Essen. Stockfotohttps://www.alamy.de/image-license-details/?v=1https://www.alamy.de/ein-tisch-in-einem-restaurant-mit-dreckigem-geschirr-nach-dem-essen-image552161781.htmlRM2R293YH–Ein Tisch in einem Restaurant mit dreckigem Geschirr nach dem Essen.
 Stapel von Gerichten Stockfotohttps://www.alamy.de/image-license-details/?v=1https://www.alamy.de/stockfoto-stapel-von-gerichten-44011430.html
Stapel von Gerichten Stockfotohttps://www.alamy.de/image-license-details/?v=1https://www.alamy.de/stockfoto-stapel-von-gerichten-44011430.htmlRMCFGW0P–Stapel von Gerichten
 Array von Parabolantennen Empfänger Stockfotohttps://www.alamy.de/image-license-details/?v=1https://www.alamy.de/stockfoto-array-von-parabolantennen-empfanger-71748287.html
Array von Parabolantennen Empfänger Stockfotohttps://www.alamy.de/image-license-details/?v=1https://www.alamy.de/stockfoto-array-von-parabolantennen-empfanger-71748287.htmlRME4MBJR–Array von Parabolantennen Empfänger
 Viele Satellitenschüsseln fest mit Balkon des Wohnhauses gebaut als Sozialwohnungen am Pallasstraße in Schöneberg Berlin Stockfotohttps://www.alamy.de/image-license-details/?v=1https://www.alamy.de/stockfoto-viele-satellitenschusseln-fest-mit-balkon-des-wohnhauses-gebaut-als-sozialwohnungen-am-pallasstrasse-in-schoneberg-berlin-20287585.html
Viele Satellitenschüsseln fest mit Balkon des Wohnhauses gebaut als Sozialwohnungen am Pallasstraße in Schöneberg Berlin Stockfotohttps://www.alamy.de/image-license-details/?v=1https://www.alamy.de/stockfoto-viele-satellitenschusseln-fest-mit-balkon-des-wohnhauses-gebaut-als-sozialwohnungen-am-pallasstrasse-in-schoneberg-berlin-20287585.htmlRMB5050H–Viele Satellitenschüsseln fest mit Balkon des Wohnhauses gebaut als Sozialwohnungen am Pallasstraße in Schöneberg Berlin
 AUSWAHL AN INDISCHEN CURRY-GERICHTE Stockfotohttps://www.alamy.de/image-license-details/?v=1https://www.alamy.de/stockfoto-auswahl-an-indischen-curry-gerichte-85762733.html
AUSWAHL AN INDISCHEN CURRY-GERICHTE Stockfotohttps://www.alamy.de/image-license-details/?v=1https://www.alamy.de/stockfoto-auswahl-an-indischen-curry-gerichte-85762733.htmlRFEYER6N–AUSWAHL AN INDISCHEN CURRY-GERICHTE
 Chinesische Gerichte vor dem Kochen in einem Restaurant in Taizhou, Zhejiang, China. 8. November 2011 Stockfotohttps://www.alamy.de/image-license-details/?v=1https://www.alamy.de/stockfoto-chinesische-gerichte-vor-dem-kochen-in-einem-restaurant-in-taizhou-zhejiang-china-8-november-2011-40160683.html
Chinesische Gerichte vor dem Kochen in einem Restaurant in Taizhou, Zhejiang, China. 8. November 2011 Stockfotohttps://www.alamy.de/image-license-details/?v=1https://www.alamy.de/stockfoto-chinesische-gerichte-vor-dem-kochen-in-einem-restaurant-in-taizhou-zhejiang-china-8-november-2011-40160683.htmlRMC99DA3–Chinesische Gerichte vor dem Kochen in einem Restaurant in Taizhou, Zhejiang, China. 8. November 2011
Petrischalen in ein Krankenhaus labatory Stockfotohttps://www.alamy.de/image-license-details/?v=1https://www.alamy.de/stockfoto-petrischalen-in-ein-krankenhaus-labatory-21920472.html
Petrischalen in ein Krankenhaus labatory Stockfotohttps://www.alamy.de/image-license-details/?v=1https://www.alamy.de/stockfoto-petrischalen-in-ein-krankenhaus-labatory-21920472.htmlRMB7JFP0–Petrischalen in ein Krankenhaus labatory
 Chinesisches Neujahr Abendessen Gerichte zu Hause feiern Stockfotohttps://www.alamy.de/image-license-details/?v=1https://www.alamy.de/stockfoto-chinesisches-neujahr-abendessen-gerichte-zu-hause-feiern-53855415.html
Chinesisches Neujahr Abendessen Gerichte zu Hause feiern Stockfotohttps://www.alamy.de/image-license-details/?v=1https://www.alamy.de/stockfoto-chinesisches-neujahr-abendessen-gerichte-zu-hause-feiern-53855415.htmlRMD3H93K–Chinesisches Neujahr Abendessen Gerichte zu Hause feiern
 Gerichte mit marokkanischen festliche hausgemachte Kekse, Selou und Tee Stockfotohttps://www.alamy.de/image-license-details/?v=1https://www.alamy.de/stockfoto-gerichte-mit-marokkanischen-festliche-hausgemachte-kekse-selou-und-tee-102251916.html
Gerichte mit marokkanischen festliche hausgemachte Kekse, Selou und Tee Stockfotohttps://www.alamy.de/image-license-details/?v=1https://www.alamy.de/stockfoto-gerichte-mit-marokkanischen-festliche-hausgemachte-kekse-selou-und-tee-102251916.htmlRFFX9YA4–Gerichte mit marokkanischen festliche hausgemachte Kekse, Selou und Tee
 Frische Äpfel und Gerichte Stockfotohttps://www.alamy.de/image-license-details/?v=1https://www.alamy.de/stockfoto-frische-apfel-und-gerichte-48261533.html
Frische Äpfel und Gerichte Stockfotohttps://www.alamy.de/image-license-details/?v=1https://www.alamy.de/stockfoto-frische-apfel-und-gerichte-48261533.htmlRFCPEE25–Frische Äpfel und Gerichte
 Ein Waschbecken voller schmutziges Geschirr und Seifenwasser. Stockfotohttps://www.alamy.de/image-license-details/?v=1https://www.alamy.de/stockfoto-ein-waschbecken-voller-schmutziges-geschirr-und-seifenwasser-33196013.html
Ein Waschbecken voller schmutziges Geschirr und Seifenwasser. Stockfotohttps://www.alamy.de/image-license-details/?v=1https://www.alamy.de/stockfoto-ein-waschbecken-voller-schmutziges-geschirr-und-seifenwasser-33196013.htmlRFBX05RW–Ein Waschbecken voller schmutziges Geschirr und Seifenwasser.
 Chinesische Künstler jonglieren Gerichte Stockfotohttps://www.alamy.de/image-license-details/?v=1https://www.alamy.de/stockfoto-chinesische-kunstler-jonglieren-gerichte-16638191.html
Chinesische Künstler jonglieren Gerichte Stockfotohttps://www.alamy.de/image-license-details/?v=1https://www.alamy.de/stockfoto-chinesische-kunstler-jonglieren-gerichte-16638191.htmlRMAWR52T–Chinesische Künstler jonglieren Gerichte
 Fleischgerichte Stockfotohttps://www.alamy.de/image-license-details/?v=1https://www.alamy.de/fleischgerichte-image268811900.html
Fleischgerichte Stockfotohttps://www.alamy.de/image-license-details/?v=1https://www.alamy.de/fleischgerichte-image268811900.htmlRMWH9C90–Fleischgerichte
 Parabolantennen, Pallasstraße, Schöneberg, Berlin, Deutschland / Schöneberg Stockfotohttps://www.alamy.de/image-license-details/?v=1https://www.alamy.de/stockfoto-parabolantennen-pallasstrasse-schoneberg-berlin-deutschland-schoneberg-103228235.html
Parabolantennen, Pallasstraße, Schöneberg, Berlin, Deutschland / Schöneberg Stockfotohttps://www.alamy.de/image-license-details/?v=1https://www.alamy.de/stockfoto-parabolantennen-pallasstrasse-schoneberg-berlin-deutschland-schoneberg-103228235.htmlRMFYXCJK–Parabolantennen, Pallasstraße, Schöneberg, Berlin, Deutschland / Schöneberg
 Frau Reinigung Geschirr Stockfotohttps://www.alamy.de/image-license-details/?v=1https://www.alamy.de/stockfoto-frau-reinigung-geschirr-20280820.html
Frau Reinigung Geschirr Stockfotohttps://www.alamy.de/image-license-details/?v=1https://www.alamy.de/stockfoto-frau-reinigung-geschirr-20280820.htmlRFB4YTB0–Frau Reinigung Geschirr
 Gerichte von Konnyaku Stockfotohttps://www.alamy.de/image-license-details/?v=1https://www.alamy.de/stockfoto-gerichte-von-konnyaku-37140811.html
Gerichte von Konnyaku Stockfotohttps://www.alamy.de/image-license-details/?v=1https://www.alamy.de/stockfoto-gerichte-von-konnyaku-37140811.htmlRFC4BWDF–Gerichte von Konnyaku
 Frau wischte sich die Gerichte. Stockfotohttps://www.alamy.de/image-license-details/?v=1https://www.alamy.de/stockfoto-frau-wischte-sich-die-gerichte-91225484.html
Frau wischte sich die Gerichte. Stockfotohttps://www.alamy.de/image-license-details/?v=1https://www.alamy.de/stockfoto-frau-wischte-sich-die-gerichte-91225484.htmlRMF8BK10–Frau wischte sich die Gerichte.
 Eine Frau beim Abwasch in heißem Wasser von einem Willis erneuerbare Energien Solar Syphon-System zur Verfügung gestellt. Stockfotohttps://www.alamy.de/image-license-details/?v=1https://www.alamy.de/stockfoto-eine-frau-beim-abwasch-in-heissem-wasser-von-einem-willis-erneuerbare-energien-solar-syphon-system-zur-verfugung-gestellt-31477122.html
Eine Frau beim Abwasch in heißem Wasser von einem Willis erneuerbare Energien Solar Syphon-System zur Verfügung gestellt. Stockfotohttps://www.alamy.de/image-license-details/?v=1https://www.alamy.de/stockfoto-eine-frau-beim-abwasch-in-heissem-wasser-von-einem-willis-erneuerbare-energien-solar-syphon-system-zur-verfugung-gestellt-31477122.htmlRMBR5WAX–Eine Frau beim Abwasch in heißem Wasser von einem Willis erneuerbare Energien Solar Syphon-System zur Verfügung gestellt.
 Vater und Kinder beim Geschirr in der Küche Stockfotohttps://www.alamy.de/image-license-details/?v=1https://www.alamy.de/vater-und-kinder-beim-geschirr-in-der-kuche-image360957796.html
Vater und Kinder beim Geschirr in der Küche Stockfotohttps://www.alamy.de/image-license-details/?v=1https://www.alamy.de/vater-und-kinder-beim-geschirr-in-der-kuche-image360957796.htmlRF2BY719T–Vater und Kinder beim Geschirr in der Küche
 Speisen in einem Restaurant Speisen Zubereitung Mahlzeiten Lebensmittelindustrie Stockfotohttps://www.alamy.de/image-license-details/?v=1https://www.alamy.de/stockfoto-speisen-in-einem-restaurant-speisen-zubereitung-mahlzeiten-lebensmittelindustrie-140085722.html
Speisen in einem Restaurant Speisen Zubereitung Mahlzeiten Lebensmittelindustrie Stockfotohttps://www.alamy.de/image-license-details/?v=1https://www.alamy.de/stockfoto-speisen-in-einem-restaurant-speisen-zubereitung-mahlzeiten-lebensmittelindustrie-140085722.htmlRMJ3WCNE–Speisen in einem Restaurant Speisen Zubereitung Mahlzeiten Lebensmittelindustrie
 Vietnamesin Abwasch auf der Straße in Hanoi Vietnam Stockfotohttps://www.alamy.de/image-license-details/?v=1https://www.alamy.de/stockfoto-vietnamesin-abwasch-auf-der-strasse-in-hanoi-vietnam-23725526.html
Vietnamesin Abwasch auf der Straße in Hanoi Vietnam Stockfotohttps://www.alamy.de/image-license-details/?v=1https://www.alamy.de/stockfoto-vietnamesin-abwasch-auf-der-strasse-in-hanoi-vietnam-23725526.htmlRMBAGP46–Vietnamesin Abwasch auf der Straße in Hanoi Vietnam
 Satellitenschüsseln an der Vorderseite der Reihenhäuser, Cilbey Straße, Tooting, Londoner Stadtteil Wandsworth, Greater London, England, Vereinigtes Königreich Stockfotohttps://www.alamy.de/image-license-details/?v=1https://www.alamy.de/satellitenschusseln-an-der-vorderseite-der-reihenhauser-cilbey-strasse-tooting-londoner-stadtteil-wandsworth-greater-london-england-vereinigtes-konigreich-image218112802.html
Satellitenschüsseln an der Vorderseite der Reihenhäuser, Cilbey Straße, Tooting, Londoner Stadtteil Wandsworth, Greater London, England, Vereinigtes Königreich Stockfotohttps://www.alamy.de/image-license-details/?v=1https://www.alamy.de/satellitenschusseln-an-der-vorderseite-der-reihenhauser-cilbey-strasse-tooting-londoner-stadtteil-wandsworth-greater-london-england-vereinigtes-konigreich-image218112802.htmlRMPJRW2X–Satellitenschüsseln an der Vorderseite der Reihenhäuser, Cilbey Straße, Tooting, Londoner Stadtteil Wandsworth, Greater London, England, Vereinigtes Königreich
 Satellitenschüssel Gerichte der Sternwarte Radioteleskop Very Large Array VLA in der Nähe von Socorro New Mexico uns USA Amerika Stockfotohttps://www.alamy.de/image-license-details/?v=1https://www.alamy.de/stockfoto-satellitenschussel-gerichte-der-sternwarte-radioteleskop-very-large-array-vla-in-der-nahe-von-socorro-new-mexico-uns-usa-amerika-13080213.html
Satellitenschüssel Gerichte der Sternwarte Radioteleskop Very Large Array VLA in der Nähe von Socorro New Mexico uns USA Amerika Stockfotohttps://www.alamy.de/image-license-details/?v=1https://www.alamy.de/stockfoto-satellitenschussel-gerichte-der-sternwarte-radioteleskop-very-large-array-vla-in-der-nahe-von-socorro-new-mexico-uns-usa-amerika-13080213.htmlRMAC8YTP–Satellitenschüssel Gerichte der Sternwarte Radioteleskop Very Large Array VLA in der Nähe von Socorro New Mexico uns USA Amerika
 AUSWAHL AN INDISCHEN CURRY-GERICHTE Stockfotohttps://www.alamy.de/image-license-details/?v=1https://www.alamy.de/stockfoto-auswahl-an-indischen-curry-gerichte-85762730.html
AUSWAHL AN INDISCHEN CURRY-GERICHTE Stockfotohttps://www.alamy.de/image-license-details/?v=1https://www.alamy.de/stockfoto-auswahl-an-indischen-curry-gerichte-85762730.htmlRFEYER6J–AUSWAHL AN INDISCHEN CURRY-GERICHTE
 Chinesische Gerichte vor dem Kochen in einem Restaurant in Taizhou, Zhejiang, China. 8. November 2011 Stockfotohttps://www.alamy.de/image-license-details/?v=1https://www.alamy.de/stockfoto-chinesische-gerichte-vor-dem-kochen-in-einem-restaurant-in-taizhou-zhejiang-china-8-november-2011-40160704.html
Chinesische Gerichte vor dem Kochen in einem Restaurant in Taizhou, Zhejiang, China. 8. November 2011 Stockfotohttps://www.alamy.de/image-license-details/?v=1https://www.alamy.de/stockfoto-chinesische-gerichte-vor-dem-kochen-in-einem-restaurant-in-taizhou-zhejiang-china-8-november-2011-40160704.htmlRMC99DAT–Chinesische Gerichte vor dem Kochen in einem Restaurant in Taizhou, Zhejiang, China. 8. November 2011
 Tablett mit Tapas-Gerichten als Executive Desk Lunch - Stockfotohttps://www.alamy.de/image-license-details/?v=1https://www.alamy.de/tablett-mit-tapas-gerichten-als-executive-desk-lunch-image355290620.html
Tablett mit Tapas-Gerichten als Executive Desk Lunch - Stockfotohttps://www.alamy.de/image-license-details/?v=1https://www.alamy.de/tablett-mit-tapas-gerichten-als-executive-desk-lunch-image355290620.htmlRF2BJ0TPM–Tablett mit Tapas-Gerichten als Executive Desk Lunch -
 Lebensmittel und Getränke, Essgeschirr/Geschirr, Tonflasche für Feldarbeiter, Höhe 27,5 cm, Italien, ca. 1930, Stockfotohttps://www.alamy.de/image-license-details/?v=1https://www.alamy.de/stockfoto-lebensmittel-und-getranke-essgeschirrgeschirr-tonflasche-fur-feldarbeiter-hohe-275-cm-italien-ca-1930-18838296.html
Lebensmittel und Getränke, Essgeschirr/Geschirr, Tonflasche für Feldarbeiter, Höhe 27,5 cm, Italien, ca. 1930, Stockfotohttps://www.alamy.de/image-license-details/?v=1https://www.alamy.de/stockfoto-lebensmittel-und-getranke-essgeschirrgeschirr-tonflasche-fur-feldarbeiter-hohe-275-cm-italien-ca-1930-18838296.htmlRMB2J4C8–Lebensmittel und Getränke, Essgeschirr/Geschirr, Tonflasche für Feldarbeiter, Höhe 27,5 cm, Italien, ca. 1930,
 Gerichte mit marokkanischen festliche hausgemachten Keksen, Nüssen und Tee Stockfotohttps://www.alamy.de/image-license-details/?v=1https://www.alamy.de/stockfoto-gerichte-mit-marokkanischen-festliche-hausgemachten-keksen-nussen-und-tee-102579378.html
Gerichte mit marokkanischen festliche hausgemachten Keksen, Nüssen und Tee Stockfotohttps://www.alamy.de/image-license-details/?v=1https://www.alamy.de/stockfoto-gerichte-mit-marokkanischen-festliche-hausgemachten-keksen-nussen-und-tee-102579378.htmlRFFXTW16–Gerichte mit marokkanischen festliche hausgemachten Keksen, Nüssen und Tee
 Frische grüne Birnen und Gerichte Stockfotohttps://www.alamy.de/image-license-details/?v=1https://www.alamy.de/stockfoto-frische-grune-birnen-und-gerichte-48261455.html
Frische grüne Birnen und Gerichte Stockfotohttps://www.alamy.de/image-license-details/?v=1https://www.alamy.de/stockfoto-frische-grune-birnen-und-gerichte-48261455.htmlRFCPEDYB–Frische grüne Birnen und Gerichte
 Eine Masse von schmutzig, schmutzig Gerichte mit Lebensmitteln Fetzen warten gewaschen werden. Stockfotohttps://www.alamy.de/image-license-details/?v=1https://www.alamy.de/stockfoto-eine-masse-von-schmutzig-schmutzig-gerichte-mit-lebensmitteln-fetzen-warten-gewaschen-werden-33195919.html
Eine Masse von schmutzig, schmutzig Gerichte mit Lebensmitteln Fetzen warten gewaschen werden. Stockfotohttps://www.alamy.de/image-license-details/?v=1https://www.alamy.de/stockfoto-eine-masse-von-schmutzig-schmutzig-gerichte-mit-lebensmitteln-fetzen-warten-gewaschen-werden-33195919.htmlRFBX05MF–Eine Masse von schmutzig, schmutzig Gerichte mit Lebensmitteln Fetzen warten gewaschen werden.
 Chinesische Künstler jonglieren Gerichte Stockfotohttps://www.alamy.de/image-license-details/?v=1https://www.alamy.de/stockfoto-chinesische-kunstler-jonglieren-gerichte-16638196.html
Chinesische Künstler jonglieren Gerichte Stockfotohttps://www.alamy.de/image-license-details/?v=1https://www.alamy.de/stockfoto-chinesische-kunstler-jonglieren-gerichte-16638196.htmlRMAWR53H–Chinesische Künstler jonglieren Gerichte
 Indische Gerichte Stockfotohttps://www.alamy.de/image-license-details/?v=1https://www.alamy.de/indische-gerichte-image268811419.html
Indische Gerichte Stockfotohttps://www.alamy.de/image-license-details/?v=1https://www.alamy.de/indische-gerichte-image268811419.htmlRMWH9BKR–Indische Gerichte
 Parabolantennen, Pallasstraße, Schöneberg, Berlin, Deutschland / Schöneberg Stockfotohttps://www.alamy.de/image-license-details/?v=1https://www.alamy.de/stockfoto-parabolantennen-pallasstrasse-schoneberg-berlin-deutschland-schoneberg-103228237.html
Parabolantennen, Pallasstraße, Schöneberg, Berlin, Deutschland / Schöneberg Stockfotohttps://www.alamy.de/image-license-details/?v=1https://www.alamy.de/stockfoto-parabolantennen-pallasstrasse-schoneberg-berlin-deutschland-schoneberg-103228237.htmlRMFYXCJN–Parabolantennen, Pallasstraße, Schöneberg, Berlin, Deutschland / Schöneberg
 Frau Reinigung Geschirr Stockfotohttps://www.alamy.de/image-license-details/?v=1https://www.alamy.de/stockfoto-frau-reinigung-geschirr-20280821.html
Frau Reinigung Geschirr Stockfotohttps://www.alamy.de/image-license-details/?v=1https://www.alamy.de/stockfoto-frau-reinigung-geschirr-20280821.htmlRFB4YTB1–Frau Reinigung Geschirr
 Gerichte von Konnyaku Stockfotohttps://www.alamy.de/image-license-details/?v=1https://www.alamy.de/stockfoto-gerichte-von-konnyaku-37140814.html
Gerichte von Konnyaku Stockfotohttps://www.alamy.de/image-license-details/?v=1https://www.alamy.de/stockfoto-gerichte-von-konnyaku-37140814.htmlRFC4BWDJ–Gerichte von Konnyaku
 Gedeck, Gerichte auf Holztisch Stockfotohttps://www.alamy.de/image-license-details/?v=1https://www.alamy.de/stockfoto-gedeck-gerichte-auf-holztisch-51218970.html
Gedeck, Gerichte auf Holztisch Stockfotohttps://www.alamy.de/image-license-details/?v=1https://www.alamy.de/stockfoto-gedeck-gerichte-auf-holztisch-51218970.htmlRMCY968X–Gedeck, Gerichte auf Holztisch
 Eine Auswahl an Gerichten im Mercato Metropolitano Elephant & Castle, gebratene Bananen und gebratener Blumenkohl aus Arabeet, London, Großbritannien Stockfotohttps://www.alamy.de/image-license-details/?v=1https://www.alamy.de/eine-auswahl-an-gerichten-im-mercato-metropolitano-elephant-castle-gebratene-bananen-und-gebratener-blumenkohl-aus-arabeet-london-grossbritannien-image478602939.html
Eine Auswahl an Gerichten im Mercato Metropolitano Elephant & Castle, gebratene Bananen und gebratener Blumenkohl aus Arabeet, London, Großbritannien Stockfotohttps://www.alamy.de/image-license-details/?v=1https://www.alamy.de/eine-auswahl-an-gerichten-im-mercato-metropolitano-elephant-castle-gebratene-bananen-und-gebratener-blumenkohl-aus-arabeet-london-grossbritannien-image478602939.htmlRM2JPJ6X3–Eine Auswahl an Gerichten im Mercato Metropolitano Elephant & Castle, gebratene Bananen und gebratener Blumenkohl aus Arabeet, London, Großbritannien
 Vater und Kinder beim Abspülen in der Küchenspüle Stockfotohttps://www.alamy.de/image-license-details/?v=1https://www.alamy.de/vater-und-kinder-beim-abspulen-in-der-kuchenspule-image360959373.html
Vater und Kinder beim Abspülen in der Küchenspüle Stockfotohttps://www.alamy.de/image-license-details/?v=1https://www.alamy.de/vater-und-kinder-beim-abspulen-in-der-kuchenspule-image360959373.htmlRF2BY73A5–Vater und Kinder beim Abspülen in der Küchenspüle
 Eine Mahlzeit bereitet ein Koch das Essen im Restaurant Vorbereitung Food Industrie Gerichte Fischfrikadellen Stockfotohttps://www.alamy.de/image-license-details/?v=1https://www.alamy.de/stockfoto-eine-mahlzeit-bereitet-ein-koch-das-essen-im-restaurant-vorbereitung-food-industrie-gerichte-fischfrikadellen-140085718.html
Eine Mahlzeit bereitet ein Koch das Essen im Restaurant Vorbereitung Food Industrie Gerichte Fischfrikadellen Stockfotohttps://www.alamy.de/image-license-details/?v=1https://www.alamy.de/stockfoto-eine-mahlzeit-bereitet-ein-koch-das-essen-im-restaurant-vorbereitung-food-industrie-gerichte-fischfrikadellen-140085718.htmlRMJ3WCNA–Eine Mahlzeit bereitet ein Koch das Essen im Restaurant Vorbereitung Food Industrie Gerichte Fischfrikadellen
 Balaleet, Harees und Margoog traditionellen persischen Golf Arabisch Küche Gerichte im Café im Souk von Manama, Bahrain Stockfotohttps://www.alamy.de/image-license-details/?v=1https://www.alamy.de/stockfoto-balaleet-harees-und-margoog-traditionellen-persischen-golf-arabisch-kuche-gerichte-im-caf-im-souk-von-manama-bahrain-109160170.html
Balaleet, Harees und Margoog traditionellen persischen Golf Arabisch Küche Gerichte im Café im Souk von Manama, Bahrain Stockfotohttps://www.alamy.de/image-license-details/?v=1https://www.alamy.de/stockfoto-balaleet-harees-und-margoog-traditionellen-persischen-golf-arabisch-kuche-gerichte-im-caf-im-souk-von-manama-bahrain-109160170.htmlRMG9GJWE–Balaleet, Harees und Margoog traditionellen persischen Golf Arabisch Küche Gerichte im Café im Souk von Manama, Bahrain
 Kommunikationsturm Satellitenschüsseln, Masten und Antennen von Valluga Station, St.Anton (Sankt Anton am Arlberg), Tirol, Österreich Stockfotohttps://www.alamy.de/image-license-details/?v=1https://www.alamy.de/stockfoto-kommunikationsturm-satellitenschusseln-masten-und-antennen-von-valluga-station-stanton-sankt-anton-am-arlberg-tirol-osterreich-76839542.html
Kommunikationsturm Satellitenschüsseln, Masten und Antennen von Valluga Station, St.Anton (Sankt Anton am Arlberg), Tirol, Österreich Stockfotohttps://www.alamy.de/image-license-details/?v=1https://www.alamy.de/stockfoto-kommunikationsturm-satellitenschusseln-masten-und-antennen-von-valluga-station-stanton-sankt-anton-am-arlberg-tirol-osterreich-76839542.htmlRMED09HA–Kommunikationsturm Satellitenschüsseln, Masten und Antennen von Valluga Station, St.Anton (Sankt Anton am Arlberg), Tirol, Österreich
 Satellitenschüssel Gerichte der Sternwarte Radioteleskop Very Large Array VLA in der Nähe von Socorro New Mexico uns USA Amerika Stockfotohttps://www.alamy.de/image-license-details/?v=1https://www.alamy.de/stockfoto-satellitenschussel-gerichte-der-sternwarte-radioteleskop-very-large-array-vla-in-der-nahe-von-socorro-new-mexico-uns-usa-amerika-13079825.html
Satellitenschüssel Gerichte der Sternwarte Radioteleskop Very Large Array VLA in der Nähe von Socorro New Mexico uns USA Amerika Stockfotohttps://www.alamy.de/image-license-details/?v=1https://www.alamy.de/stockfoto-satellitenschussel-gerichte-der-sternwarte-radioteleskop-very-large-array-vla-in-der-nahe-von-socorro-new-mexico-uns-usa-amerika-13079825.htmlRMAC8XMJ–Satellitenschüssel Gerichte der Sternwarte Radioteleskop Very Large Array VLA in der Nähe von Socorro New Mexico uns USA Amerika
 AUSWAHL AN INDISCHEN CURRY-GERICHTE Stockfotohttps://www.alamy.de/image-license-details/?v=1https://www.alamy.de/stockfoto-auswahl-an-indischen-curry-gerichte-85762735.html
AUSWAHL AN INDISCHEN CURRY-GERICHTE Stockfotohttps://www.alamy.de/image-license-details/?v=1https://www.alamy.de/stockfoto-auswahl-an-indischen-curry-gerichte-85762735.htmlRFEYER6R–AUSWAHL AN INDISCHEN CURRY-GERICHTE
 Chinesische Gerichte vor dem Kochen in einem Restaurant in Taizhou, Zhejiang, China. 8. November 2011 Stockfotohttps://www.alamy.de/image-license-details/?v=1https://www.alamy.de/stockfoto-chinesische-gerichte-vor-dem-kochen-in-einem-restaurant-in-taizhou-zhejiang-china-8-november-2011-40160691.html
Chinesische Gerichte vor dem Kochen in einem Restaurant in Taizhou, Zhejiang, China. 8. November 2011 Stockfotohttps://www.alamy.de/image-license-details/?v=1https://www.alamy.de/stockfoto-chinesische-gerichte-vor-dem-kochen-in-einem-restaurant-in-taizhou-zhejiang-china-8-november-2011-40160691.htmlRMC99DAB–Chinesische Gerichte vor dem Kochen in einem Restaurant in Taizhou, Zhejiang, China. 8. November 2011
 WEIßEM GESCHIRR TROCKNEN Stockfotohttps://www.alamy.de/image-license-details/?v=1https://www.alamy.de/stockfoto-weissem-geschirr-trocknen-19498896.html
WEIßEM GESCHIRR TROCKNEN Stockfotohttps://www.alamy.de/image-license-details/?v=1https://www.alamy.de/stockfoto-weissem-geschirr-trocknen-19498896.htmlRFB3M714–WEIßEM GESCHIRR TROCKNEN
 Tablett mit Tapas-Gerichten als Executive Desk Lunch - Stockfotohttps://www.alamy.de/image-license-details/?v=1https://www.alamy.de/tablett-mit-tapas-gerichten-als-executive-desk-lunch-image355290638.html
Tablett mit Tapas-Gerichten als Executive Desk Lunch - Stockfotohttps://www.alamy.de/image-license-details/?v=1https://www.alamy.de/tablett-mit-tapas-gerichten-als-executive-desk-lunch-image355290638.htmlRF2BJ0TRA–Tablett mit Tapas-Gerichten als Executive Desk Lunch -
 Vier Arten von Salz in weißem Geschirr hautnah Stockfotohttps://www.alamy.de/image-license-details/?v=1https://www.alamy.de/stockfoto-vier-arten-von-salz-in-weissem-geschirr-hautnah-95332494.html
Vier Arten von Salz in weißem Geschirr hautnah Stockfotohttps://www.alamy.de/image-license-details/?v=1https://www.alamy.de/stockfoto-vier-arten-von-salz-in-weissem-geschirr-hautnah-95332494.htmlRFFF2NFX–Vier Arten von Salz in weißem Geschirr hautnah
 Parabolantennen und Sender Antennen Stockfotohttps://www.alamy.de/image-license-details/?v=1https://www.alamy.de/stockfoto-parabolantennen-und-sender-antennen-41430596.html
Parabolantennen und Sender Antennen Stockfotohttps://www.alamy.de/image-license-details/?v=1https://www.alamy.de/stockfoto-parabolantennen-und-sender-antennen-41430596.htmlRMCBB944–Parabolantennen und Sender Antennen
 Eine Hausfrau bietet ihr Gericht Schwamm zu helfen, Geschirr spülen Stockfotohttps://www.alamy.de/image-license-details/?v=1https://www.alamy.de/stockfoto-eine-hausfrau-bietet-ihr-gericht-schwamm-zu-helfen-geschirr-spulen-33195760.html
Eine Hausfrau bietet ihr Gericht Schwamm zu helfen, Geschirr spülen Stockfotohttps://www.alamy.de/image-license-details/?v=1https://www.alamy.de/stockfoto-eine-hausfrau-bietet-ihr-gericht-schwamm-zu-helfen-geschirr-spulen-33195760.htmlRFBX05ET–Eine Hausfrau bietet ihr Gericht Schwamm zu helfen, Geschirr spülen
 Chinesische Künstler jonglieren Gerichte Stockfotohttps://www.alamy.de/image-license-details/?v=1https://www.alamy.de/stockfoto-chinesische-kunstler-jonglieren-gerichte-16638198.html
Chinesische Künstler jonglieren Gerichte Stockfotohttps://www.alamy.de/image-license-details/?v=1https://www.alamy.de/stockfoto-chinesische-kunstler-jonglieren-gerichte-16638198.htmlRMAWR53K–Chinesische Künstler jonglieren Gerichte
 Fischgerichte. Stockfotohttps://www.alamy.de/image-license-details/?v=1https://www.alamy.de/fischgerichte-image268860021.html
Fischgerichte. Stockfotohttps://www.alamy.de/image-license-details/?v=1https://www.alamy.de/fischgerichte-image268860021.htmlRMWHBHKH–Fischgerichte.
 Frau mit Gerichten, Saquisili Markt, Ecuador Stockfotohttps://www.alamy.de/image-license-details/?v=1https://www.alamy.de/stockfoto-frau-mit-gerichten-saquisili-markt-ecuador-19963519.html
Frau mit Gerichten, Saquisili Markt, Ecuador Stockfotohttps://www.alamy.de/image-license-details/?v=1https://www.alamy.de/stockfoto-frau-mit-gerichten-saquisili-markt-ecuador-19963519.htmlRMB4DBJR–Frau mit Gerichten, Saquisili Markt, Ecuador
 Frau Reinigung Geschirr Stockfotohttps://www.alamy.de/image-license-details/?v=1https://www.alamy.de/stockfoto-frau-reinigung-geschirr-20280822.html
Frau Reinigung Geschirr Stockfotohttps://www.alamy.de/image-license-details/?v=1https://www.alamy.de/stockfoto-frau-reinigung-geschirr-20280822.htmlRFB4YTB2–Frau Reinigung Geschirr
 Karpfen-Gerichte Stockfotohttps://www.alamy.de/image-license-details/?v=1https://www.alamy.de/stockfoto-karpfen-gerichte-33824546.html
Karpfen-Gerichte Stockfotohttps://www.alamy.de/image-license-details/?v=1https://www.alamy.de/stockfoto-karpfen-gerichte-33824546.htmlRFBY0RFE–Karpfen-Gerichte
 Satellitenschüsseln in einen hölzernen Turm Stockfotohttps://www.alamy.de/image-license-details/?v=1https://www.alamy.de/stockfoto-satellitenschusseln-in-einen-holzernen-turm-53796360.html
Satellitenschüsseln in einen hölzernen Turm Stockfotohttps://www.alamy.de/image-license-details/?v=1https://www.alamy.de/stockfoto-satellitenschusseln-in-einen-holzernen-turm-53796360.htmlRMD3EHPG–Satellitenschüsseln in einen hölzernen Turm
 Äthiopische Gerichte auf einen Lebensmittelmarkt (gehobene Sonntag, alte Truman Brauerei Boiler House Food Hall, Brick Lane, London, UK) Stockfotohttps://www.alamy.de/image-license-details/?v=1https://www.alamy.de/stockfoto-athiopische-gerichte-auf-einen-lebensmittelmarkt-gehobene-sonntag-alte-truman-brauerei-boiler-house-food-hall-brick-lane-london-uk-145872273.html
Äthiopische Gerichte auf einen Lebensmittelmarkt (gehobene Sonntag, alte Truman Brauerei Boiler House Food Hall, Brick Lane, London, UK) Stockfotohttps://www.alamy.de/image-license-details/?v=1https://www.alamy.de/stockfoto-athiopische-gerichte-auf-einen-lebensmittelmarkt-gehobene-sonntag-alte-truman-brauerei-boiler-house-food-hall-brick-lane-london-uk-145872273.htmlRMJD91G1–Äthiopische Gerichte auf einen Lebensmittelmarkt (gehobene Sonntag, alte Truman Brauerei Boiler House Food Hall, Brick Lane, London, UK)
 Vater und Kinder beim Abspülen in der Küchenspüle Stockfotohttps://www.alamy.de/image-license-details/?v=1https://www.alamy.de/vater-und-kinder-beim-abspulen-in-der-kuchenspule-image360959302.html
Vater und Kinder beim Abspülen in der Küchenspüle Stockfotohttps://www.alamy.de/image-license-details/?v=1https://www.alamy.de/vater-und-kinder-beim-abspulen-in-der-kuchenspule-image360959302.htmlRF2BY737J–Vater und Kinder beim Abspülen in der Küchenspüle
 Luftaufnahme von Kommunikation Parabolantennen in Tackley, North Oxford, UK Stockfotohttps://www.alamy.de/image-license-details/?v=1https://www.alamy.de/stockfoto-luftaufnahme-von-kommunikation-parabolantennen-in-tackley-north-oxford-uk-112599003.html
Luftaufnahme von Kommunikation Parabolantennen in Tackley, North Oxford, UK Stockfotohttps://www.alamy.de/image-license-details/?v=1https://www.alamy.de/stockfoto-luftaufnahme-von-kommunikation-parabolantennen-in-tackley-north-oxford-uk-112599003.htmlRMGF594Y–Luftaufnahme von Kommunikation Parabolantennen in Tackley, North Oxford, UK
 Tafel mit Speisekarten am Calangute Beach; Goa; Indien; Asien Stockfotohttps://www.alamy.de/image-license-details/?v=1https://www.alamy.de/stockfoto-tafel-mit-speisekarten-am-calangute-beach-goa-indien-asien-83615784.html
Tafel mit Speisekarten am Calangute Beach; Goa; Indien; Asien Stockfotohttps://www.alamy.de/image-license-details/?v=1https://www.alamy.de/stockfoto-tafel-mit-speisekarten-am-calangute-beach-goa-indien-asien-83615784.htmlRMET10P0–Tafel mit Speisekarten am Calangute Beach; Goa; Indien; Asien
 Glas Avocado Gerichte Stockfotohttps://www.alamy.de/image-license-details/?v=1https://www.alamy.de/glas-avocado-gerichte-image235428464.html
Glas Avocado Gerichte Stockfotohttps://www.alamy.de/image-license-details/?v=1https://www.alamy.de/glas-avocado-gerichte-image235428464.htmlRMRK0KBC–Glas Avocado Gerichte

